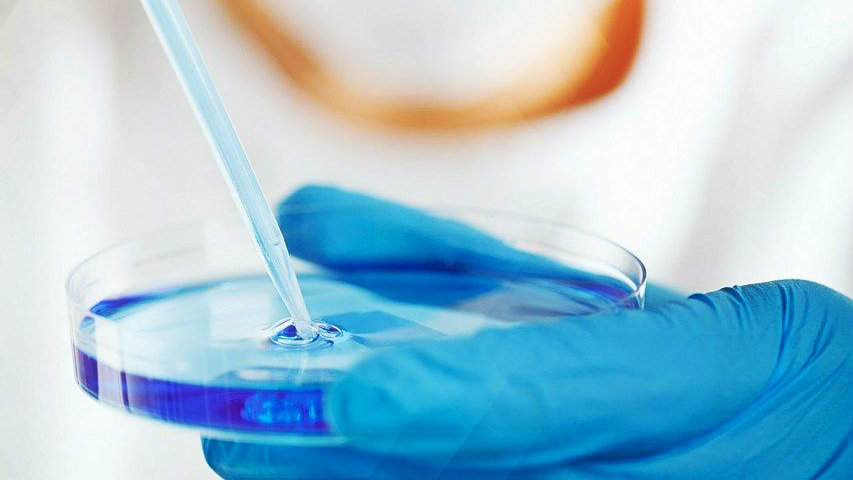

Whatsapp Kettenbrief Coronavirus Selbstdiagnose Ist Fake N Joy Digitales
www.n-joy.de

Lustige Coronavirus Witze 19 Geniale Bilder Die Uns Durchhalten Lassen Watson
www.watson.ch

Abbott S Fast 5 15 Minute Easy To Use Covid 19 Antigen Test Receives Fda Emergency Use Authorization Mobile App Displays Test Results To Help Our Return To Daily Life Ramping Production To 50 Million Tests A
abbott.mediaroom.com

Wie Sich Die Corona Lage In Reutlingen Und Der Region Vom 20 Bis Zum 26 Marz Entwickelt Hat Reutlingen Reutlinger General Anzeiger Gea De
www.gea.de

Abbott S Fast 5 15 Minute Easy To Use Covid 19 Antigen Test Receives Fda Emergency Use Authorization Mobile App Displays Test Results To Help Our Return To Daily Life Ramping Production To 50 Million Tests A
abbott.mediaroom.com

Corona So Funktioniert Der Schwindel Kinder Verstehen De
www.kinder-verstehen.de

Wie Sich Die Corona Lage In Reutlingen Und Der Region Vom 20 Bis Zum 26 Marz Entwickelt Hat Reutlingen Reutlinger General Anzeiger Gea De
www.gea.de

Corona In Bayern Polizei Droht Mit Anzeigen See Stege Wegen Grossen Andrangs Gesperrt Bayern
www.merkur.de

Corona Selbsttest Lustige Bilder Spruche Witze Echt Lustig In 2020 Lustige Zitate Und Spruche Spruche Leben Lustig Witzige Bilder Spruche
www.pinterest.es

Corona 9 Monate Spater In 2020 Urkomische Zitate Aufmunternde Spruche Freunde Zitate Lustig
www.pinterest.co.kr

Whatsapp Kettenbrief Coronavirus Selbstdiagnose Ist Fake N Joy Digitales
www.n-joy.de

Kaufdex On Twitter Fieberschnelltest Test Auf Das Coronavirus Ist Das Echt Meinungen Aus Twitter Hjbertschi Schrieb Immunologe Fordert Alle Testen Anders Sei Der Kampf Gegen Corona Nicht Mehr Zu Gewinnen Heimliche
twitter.com

Abbott S Fast 5 15 Minute Easy To Use Covid 19 Antigen Test Receives Fda Emergency Use Authorization Mobile App Displays Test Results To Help Our Return To Daily Life Ramping Production To 50 Million Tests A
abbott.mediaroom.com

Abbott S Fast 5 15 Minute Easy To Use Covid 19 Antigen Test Receives Fda Emergency Use Authorization Mobile App Displays Test Results To Help Our Return To Daily Life Ramping Production To 50 Million Tests A
abbott.mediaroom.com

Schnelltests Aus China Eingetroffen Lustige Bilder Spruche Witze Echt Lustig
debeste.de